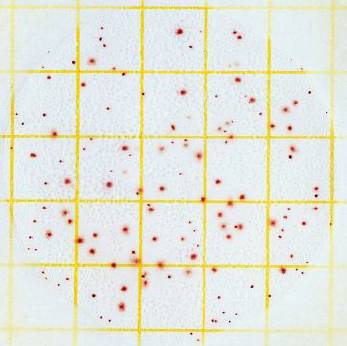

A mikrobák QMAFAnM (TBC) (mikrobiológia - tárgyak tanulmányi - élelmiszer, takarmány, a nyersanyagok,

Növekedési Bacillus cereus ATCC 11778 Plate Count agar, Cat. N 105.463
Száma mezofil aerob és fakultatív anaerob mikroorganizmusok (QMAFAnM)
Számszerűsítése mezofil aerob és fakultatív anaerob mikroorganizmusok (QMAFAnM vagy teljes mikrobaszám, TBC) egy becsült száma csoportok egészségügyi mutató mikroorganizmusok. Részeként QMAFAnM képviselő különböző taxonómiai csoportok mikroorganizmusok - baktériumok, élesztők, gombák. A teljes szám mutatja a higiéniai termék állapota, ennek mértékét a szennyeződés mikroflóra. Optimális hőmérséklet a növekedés QMAFAnM 35-37 ° C (aerob körülmények között); hőmérséklet korlátozza a növekedést - belül 20-45 ° C mezofil mikroorganizmusok találhatók a szervezetben a melegvérű állatok és vyzhivaayut talajban, víz, levegő.
QMAFAnM - a leggyakoribb teszt mikrobiológiai biztonságát. Ez az indikátor használható univerzálisan, hogy értékelje a termékek minőségét, kivéve azokat, amelyekben a specifikus mikrobiális tenyészetek alkalmazunk (így például, sör, kuvasz, tejtermékek, stb). QMAFAnM index értéke sok tényezőtől függ. A legfontosabb - a hőkezelés terméket módban, a hőmérsékleti viszonyok a szállítás során, a tárolás és értékesítés, a termék nedvességtartalma és a relatív páratartalom, az oxigén jelenléte, a termék savassága, stb Növelése QMAFAnM jelzi reprodukciója mikroorganizmusok, beleértve a kórokozókat, és lehetnek mikroorganizmusok okozza a termék pazarlását (például penészek).
A fogyasztó index QMAFAnM (TMC) jelenti a minőség, a frissesség és az élelmiszer-biztonságot. Ugyanakkor, a termék minőségének értékelése számos korlátja van csak ez a mutató. Először is, ez csak a közös, mennyiségi mikroorganizmusok, mint a tanulmány nem tekinthető patogén, opportunista, hidegkedvelő és termofil mikroorganizmusok. Másodszor, az eljárás elfogadhatatlan tartalmú termékek technológiai és speciális mikroflóra.
Eljárás meghatározására QMAFAnM vetés agarban táptalajon alapuló vetés termék vagy ennek hígításai a táptalajba, inkubálás és a számolás összes termesztett telepeket.
Van is egy módszer meghatározására MPN (legvalószínűbb szám) QMAFAnM. Ez alapján a termék vetés és / vagy hígítás a termék minta folyékony közegben, inkubáljuk növények regisztrált látható a mikrobiális növekedés jelei, tenyésztjük (ha szükséges) a táptalajból agar táptalajon, hogy erősítse meg a mikroorganizmusok növekedését, számolás számuk a MPN táblázat.
Meghatározása QMAFAnM a petrifilm 3M Petrifilm (AC)
Alternatív (gyorsított) Módszerek
Ahhoz, hogy gyorsítsa fel a meghatározás QMAFAnM mintákat ajánlott petrifilm 3M TM Petrifilm aerob szám Plate (AC). Petrifilm 3M TM Petrifilm aerob szám Plate (AC) tartalmaz egy kész tápközeg gélt (kikeményíthető szobahőmérsékleten), és egy tetrazólium mutató, amely megkönnyíti a kolónia számlálást petrifilm.
Általános jellemzői az élelmiszertermék QMAFAnM